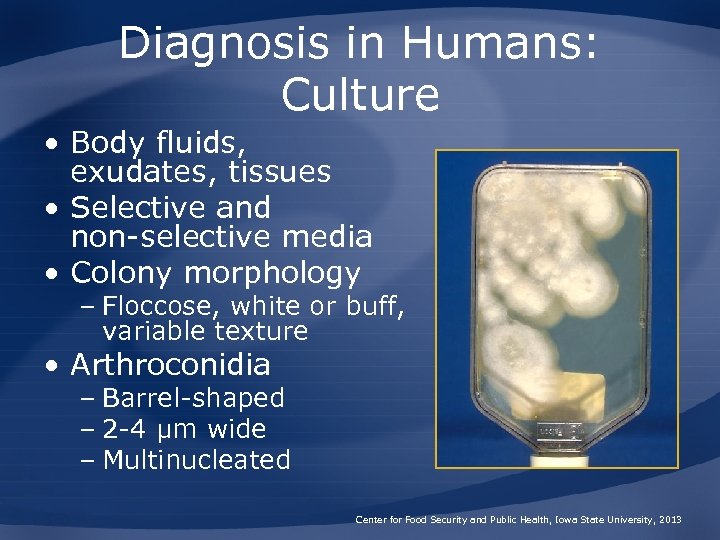
Diagnosis in Humans: Culture • Body fluids, exudates, tissues • Selective and non-selective media

3da36de1ef3dac7d4b541c51fd1d0ece.ppt
- Количество слайдов: 56
 Coccidioidomycosis Valley Fever, San Joaquin Valley Fever, Desert Rheumatism, Posadas-Wernicke Disease, Coccidioidal Granuloma
Coccidioidomycosis Valley Fever, San Joaquin Valley Fever, Desert Rheumatism, Posadas-Wernicke Disease, Coccidioidal Granuloma
 Overview • Organism • History • Epidemiology • Transmission • Disease in Humans • Disease in Animals • Prevention and Control Center for Food Security and Public Health, Iowa State University, 2013
Overview • Organism • History • Epidemiology • Transmission • Disease in Humans • Disease in Animals • Prevention and Control Center for Food Security and Public Health, Iowa State University, 2013
 THE ORGANISM
THE ORGANISM
 The Organism • Dimorphic, soil-borne fungi – Coccidioides immitis – C. posadasii • Minor differences – None in pathogenicity • Grows in semiarid regions – Esp. with sandy, alkaline soil – Also extreme temperatures and high salinity Center for Food Security and Public Health, Iowa State University, 2013
The Organism • Dimorphic, soil-borne fungi – Coccidioides immitis – C. posadasii • Minor differences – None in pathogenicity • Grows in semiarid regions – Esp. with sandy, alkaline soil – Also extreme temperatures and high salinity Center for Food Security and Public Health, Iowa State University, 2013
 Life Cycle • Two asexual reproductive structures – Arthroconidia • Grows in environment • Infectious to humans/animals – Spherules with endospores • In the body Center for Food Security and Public Health, Iowa State University, 2013
Life Cycle • Two asexual reproductive structures – Arthroconidia • Grows in environment • Infectious to humans/animals – Spherules with endospores • In the body Center for Food Security and Public Health, Iowa State University, 2013
 HISTORY
HISTORY
 History • Discovered in Argentina, 1892 – Soldier, cutaneous lesions • Additional research in areas of endemicity – San Joaquin Valley • Migrants from the Midwest – WW II military recruits, prisoners of war, Japanese held in internment camps • Cases continue to occur in U. S. Center for Food Security and Public Health, Iowa State University, 2013
History • Discovered in Argentina, 1892 – Soldier, cutaneous lesions • Additional research in areas of endemicity – San Joaquin Valley • Migrants from the Midwest – WW II military recruits, prisoners of war, Japanese held in internment camps • Cases continue to occur in U. S. Center for Food Security and Public Health, Iowa State University, 2013
 EPIDEMIOLOGY
EPIDEMIOLOGY
 Geographic Distribution • Western hemisphere – U. S. – Mexico – Central and South America • Endemic in southwestern U. S. – Arizona – New Mexico – West Texas – Central and Southern California Center for Food Security and Public Health, Iowa State University, 2013
Geographic Distribution • Western hemisphere – U. S. – Mexico – Central and South America • Endemic in southwestern U. S. – Arizona – New Mexico – West Texas – Central and Southern California Center for Food Security and Public Health, Iowa State University, 2013
 Endemic Areas in the U. S. Center for Food Security and Public Health, Iowa State University, 2013
Endemic Areas in the U. S. Center for Food Security and Public Health, Iowa State University, 2013
 Risk Factors for Infection • Dust exposure a risk factor • Occupational groups at risk – Farmers, construction workers • Weather-related peaks – Wet followed by dry, windy periods – Earthquakes, windstorms Center for Food Security and Public Health, Iowa State University, 2013
Risk Factors for Infection • Dust exposure a risk factor • Occupational groups at risk – Farmers, construction workers • Weather-related peaks – Wet followed by dry, windy periods – Earthquakes, windstorms Center for Food Security and Public Health, Iowa State University, 2013
 Risk Factors for Infection • Immunocompromised persons at risk – HIV-1 patients with decreased CD 4 T cell counts – Organ transplant patients – Lymphoma patients – People receiving long-term corticosteroids – Pregnant women – Elderly Center for Food Security and Public Health, Iowa State University, 2013
Risk Factors for Infection • Immunocompromised persons at risk – HIV-1 patients with decreased CD 4 T cell counts – Organ transplant patients – Lymphoma patients – People receiving long-term corticosteroids – Pregnant women – Elderly Center for Food Security and Public Health, Iowa State University, 2013
 Morbidity and Mortality: Humans • Southwest U. S. – Prevalence 10 -70% • Illness severity – 60% cases asymptomatic to mild – 40% cases become ill • 90% infections limited to lungs • Case fatality rate – Varies with location of organism and treatment Center for Food Security and Public Health, Iowa State University, 2013
Morbidity and Mortality: Humans • Southwest U. S. – Prevalence 10 -70% • Illness severity – 60% cases asymptomatic to mild – 40% cases become ill • 90% infections limited to lungs • Case fatality rate – Varies with location of organism and treatment Center for Food Security and Public Health, Iowa State University, 2013
 Number of US Valley Fever Cases, 1995 -2011 Center for Food Security and Public Health, Iowa State University, 2013
Number of US Valley Fever Cases, 1995 -2011 Center for Food Security and Public Health, Iowa State University, 2013
 Geographic Distribution of Coccidioidomycosis in persons >65 years of age, U. S. , 1999 -2008 Baddley JW, Winthrop KL, Patkar NM et al. Geographic Distribution of Endemic Fungal Infections among Older Persons, United States. Emerging Infectious Diseases. 2011; 17(9). Center for Food Security and Public Health, Iowa State University, 2013
Geographic Distribution of Coccidioidomycosis in persons >65 years of age, U. S. , 1999 -2008 Baddley JW, Winthrop KL, Patkar NM et al. Geographic Distribution of Endemic Fungal Infections among Older Persons, United States. Emerging Infectious Diseases. 2011; 17(9). Center for Food Security and Public Health, Iowa State University, 2013
 TRANSMISSION
TRANSMISSION
 Transmission • Humans, animals= accidental hosts • Routes of transmission – Inhalation – Inoculation (penetrating objects) – Dust-covered fomites • Communicability – Direct transmission between people or animals very rare Center for Food Security and Public Health, Iowa State University, 2013
Transmission • Humans, animals= accidental hosts • Routes of transmission – Inhalation – Inoculation (penetrating objects) – Dust-covered fomites • Communicability – Direct transmission between people or animals very rare Center for Food Security and Public Health, Iowa State University, 2013
 Transmission Center for Food Security and Public Health, Iowa State University, 2013
Transmission Center for Food Security and Public Health, Iowa State University, 2013
 DISEASE IN HUMANS
DISEASE IN HUMANS
 Incubation Period in Humans • Primary pulmonary form – Usually 1 -3 weeks • Disseminated disease, chronic pulmonary form – Can occur months to years after initial infection Center for Food Security and Public Health, Iowa State University, 2013
Incubation Period in Humans • Primary pulmonary form – Usually 1 -3 weeks • Disseminated disease, chronic pulmonary form – Can occur months to years after initial infection Center for Food Security and Public Health, Iowa State University, 2013
 Primary Pulmonary Coccidioidomycosis • Acute disease form – Most asymptomatic or mild • Symptomatic disease – Often flu-like – May resemble pneumonia – Skin lesions • 10 -50% of patients with pulmonary disease Center for Food Security and Public Health, Iowa State University, 2013
Primary Pulmonary Coccidioidomycosis • Acute disease form – Most asymptomatic or mild • Symptomatic disease – Often flu-like – May resemble pneumonia – Skin lesions • 10 -50% of patients with pulmonary disease Center for Food Security and Public Health, Iowa State University, 2013
 Primary Pulmonary Coccidioidomycosis • Severe disease more common if immunosuppressed • Mild cases often self-limited • Pulmonary nodules may persist – Incidental finding on chest x-rays – Distinguish from other conditions Center for Food Security and Public Health, Iowa State University, 2013
Primary Pulmonary Coccidioidomycosis • Severe disease more common if immunosuppressed • Mild cases often self-limited • Pulmonary nodules may persist – Incidental finding on chest x-rays – Distinguish from other conditions Center for Food Security and Public Health, Iowa State University, 2013
 Progressive Pulmonary Coccidioidomycosis • Clinical signs do not resolve – Chronic and progressive disease • Lesions – Nodular or cavitary in lungs – Cavitary lung disease with fibrosis – Miliary pulmonary dissemination • Disease usually limited to respiratory tract Center for Food Security and Public Health, Iowa State University, 2013
Progressive Pulmonary Coccidioidomycosis • Clinical signs do not resolve – Chronic and progressive disease • Lesions – Nodular or cavitary in lungs – Cavitary lung disease with fibrosis – Miliary pulmonary dissemination • Disease usually limited to respiratory tract Center for Food Security and Public Health, Iowa State University, 2013
 Disseminated Coccidioidomycosis • Small percentage of cases • Often acute – Can be rapidly fatal without treatment • May also progress slowly – Periods of remission and recurrence • Tissues affected – Skin, regional lymph nodes, bones, joints, visceral organs, testes – Clinical signs vary Center for Food Security and Public Health, Iowa State University, 2013
Disseminated Coccidioidomycosis • Small percentage of cases • Often acute – Can be rapidly fatal without treatment • May also progress slowly – Periods of remission and recurrence • Tissues affected – Skin, regional lymph nodes, bones, joints, visceral organs, testes – Clinical signs vary Center for Food Security and Public Health, Iowa State University, 2013
 Disseminated Coccidioidomycosis: Coccidioidal Meningitis • Symptoms – Fever, headache, cognitive impairment – Inflammation can lead to vasculitis, stroke, or hydrocephalus • Untreated cases – Death almost always within 2 years • Other possible outcomes – Encephalitis, mass-occupying lesions, brain abscesses, aneurysms Center for Food Security and Public Health, Iowa State University, 2013
Disseminated Coccidioidomycosis: Coccidioidal Meningitis • Symptoms – Fever, headache, cognitive impairment – Inflammation can lead to vasculitis, stroke, or hydrocephalus • Untreated cases – Death almost always within 2 years • Other possible outcomes – Encephalitis, mass-occupying lesions, brain abscesses, aneurysms Center for Food Security and Public Health, Iowa State University, 2013
 Primary Cutaneous Coccidioidomycosis • Rare – Caused by direct skin inoculation • Lesions – Chancriform ulcerated nodule/plaque – Can spread along lymphatics and cause regional lymphadenopathy • Often heals spontaneously if immunocompetent Center for Food Security and Public Health, Iowa State University, 2013
Primary Cutaneous Coccidioidomycosis • Rare – Caused by direct skin inoculation • Lesions – Chancriform ulcerated nodule/plaque – Can spread along lymphatics and cause regional lymphadenopathy • Often heals spontaneously if immunocompetent Center for Food Security and Public Health, Iowa State University, 2013
 Coccidioidomycosis in the Immunosuppressed • More susceptible to infection • Previous infections can be reactivated • Symptoms of disease – Fatal pulmonary disease most common – Other sites may be affected if organism disseminates Center for Food Security and Public Health, Iowa State University, 2013
Coccidioidomycosis in the Immunosuppressed • More susceptible to infection • Previous infections can be reactivated • Symptoms of disease – Fatal pulmonary disease most common – Other sites may be affected if organism disseminates Center for Food Security and Public Health, Iowa State University, 2013
 Diagnosis in Humans: Direct Observation • Visualization of organism – Respiratory secretions – Pleural fluid – Tissues, exudates • Spherules – Most 20 -80 μm – Contain endospores • Multiple stains effective Center for Food Security and Public Health, Iowa State University, 2013
Diagnosis in Humans: Direct Observation • Visualization of organism – Respiratory secretions – Pleural fluid – Tissues, exudates • Spherules – Most 20 -80 μm – Contain endospores • Multiple stains effective Center for Food Security and Public Health, Iowa State University, 2013
Diagnosis in Humans: Culture • Body fluids, exudates, tissues • Selective and non-selective media • Colony morphology – Floccose, white or buff, variable texture • Arthroconidia – Barrel-shaped – 2 -4 μm wide – Multinucleated Center for Food Security and Public Health, Iowa State University, 2013
Diagnosis in Humans: Culture • Body fluids, exudates, tissues • Selective and non-selective media • Colony morphology – Floccose, white or buff, variable texture • Arthroconidia – Barrel-shaped – 2 -4 μm wide – Multinucleated Center for Food Security and Public Health, Iowa State University, 2013
 Diagnosis in Humans: Serology • Assays – ELISA – Immunodiffusion – Complement fixation • Ig. G titer correlated with severity • Limitations – Early cases may be seronegative – Immunocompromised patients may have poor immune responses Center for Food Security and Public Health, Iowa State University, 2013
Diagnosis in Humans: Serology • Assays – ELISA – Immunodiffusion – Complement fixation • Ig. G titer correlated with severity • Limitations – Early cases may be seronegative – Immunocompromised patients may have poor immune responses Center for Food Security and Public Health, Iowa State University, 2013
 Diagnosis in Humans: Additional Tests • Coccidioidin/spherulin skin test – Epidemiological studies – Reagents no longer available • PCR – Assays in development Center for Food Security and Public Health, Iowa State University, 2013
Diagnosis in Humans: Additional Tests • Coccidioidin/spherulin skin test – Epidemiological studies – Reagents no longer available • PCR – Assays in development Center for Food Security and Public Health, Iowa State University, 2013
 Treatment in Humans • Options – Antifungal drugs – Surgical excision/debridement • Some cases may resolve without treatment • Lifetime treatment may be necessary – E. g. , HIV-1 infected patients with low CD 4 cell counts Center for Food Security and Public Health, Iowa State University, 2013
Treatment in Humans • Options – Antifungal drugs – Surgical excision/debridement • Some cases may resolve without treatment • Lifetime treatment may be necessary – E. g. , HIV-1 infected patients with low CD 4 cell counts Center for Food Security and Public Health, Iowa State University, 2013
 DISEASE IN ANIMALS
DISEASE IN ANIMALS
 Species Affected • Clinical cases common – Dogs, llamas – Non-human primates • Disease less common – Cats – Horses • Disease rare – Cattle, sheep, pigs Center for Food Security and Public Health, Iowa State University, 2013
Species Affected • Clinical cases common – Dogs, llamas – Non-human primates • Disease less common – Cats – Horses • Disease rare – Cattle, sheep, pigs Center for Food Security and Public Health, Iowa State University, 2013
 Incubation in Animals • Primary pulmonary infection – Usually symptomatic within 1 -4 weeks • Disseminated disease – Months to years after initial exposure • Illness similar to human disease – Primarily respiratory disease – Dissemination to any tissue/organ occurs (varies by species) Center for Food Security and Public Health, Iowa State University, 2013
Incubation in Animals • Primary pulmonary infection – Usually symptomatic within 1 -4 weeks • Disseminated disease – Months to years after initial exposure • Illness similar to human disease – Primarily respiratory disease – Dissemination to any tissue/organ occurs (varies by species) Center for Food Security and Public Health, Iowa State University, 2013
 Disease in Dogs • Infection may be subclinical • Clinical disease – Primary pulmonary most common • Chronic chough • Weight loss • Solitary lung nodules – Disseminated disease • Bones (appendicular skeleton) • CNS (granulomatous) Center for Food Security and Public Health, Iowa State University, 2013
Disease in Dogs • Infection may be subclinical • Clinical disease – Primary pulmonary most common • Chronic chough • Weight loss • Solitary lung nodules – Disseminated disease • Bones (appendicular skeleton) • CNS (granulomatous) Center for Food Security and Public Health, Iowa State University, 2013
 Morbidity and Mortality: Dogs • Infection common in endemic areas – 70% infections subclinical – Young dogs most affected – Outdoor exposure a risk factor – Disease occurs in 20% of symptomatic dogs Center for Food Security and Public Health, Iowa State University, 2013
Morbidity and Mortality: Dogs • Infection common in endemic areas – 70% infections subclinical – Young dogs most affected – Outdoor exposure a risk factor – Disease occurs in 20% of symptomatic dogs Center for Food Security and Public Health, Iowa State University, 2013
 Disease in Cats • Clinical disease – Skin lesions most common • Non-healing dermatitis • Ulcers, masses, abscesses – Regional lymphadenopathy – Other non-specific signs • Sites of dissemination – Similar to dogs – Clinical signs variable Center for Food Security and Public Health, Iowa State University, 2013
Disease in Cats • Clinical disease – Skin lesions most common • Non-healing dermatitis • Ulcers, masses, abscesses – Regional lymphadenopathy – Other non-specific signs • Sites of dissemination – Similar to dogs – Clinical signs variable Center for Food Security and Public Health, Iowa State University, 2013
 Morbidity and Mortality: Cats • Few reported cases – May be resistant compared to dogs • Recognized clinical cases often serious – Middle-aged cats • No link to immunosuppression – FIV, Fe. LV Center for Food Security and Public Health, Iowa State University, 2013
Morbidity and Mortality: Cats • Few reported cases – May be resistant compared to dogs • Recognized clinical cases often serious – Middle-aged cats • No link to immunosuppression – FIV, Fe. LV Center for Food Security and Public Health, Iowa State University, 2013
 Disease in Horses • Most reported cases disseminated • Pulmonary disease • Other signs – Osteomyelitis – Mastitis – Abortion – Cutaneous/soft tissue – Weight loss Center for Food Security and Public Health, Iowa State University, 2013
Disease in Horses • Most reported cases disseminated • Pulmonary disease • Other signs – Osteomyelitis – Mastitis – Abortion – Cutaneous/soft tissue – Weight loss Center for Food Security and Public Health, Iowa State University, 2013
 Disease in Other Species • Llamas – Particularly susceptible – Disseminated disease • Other species – Cattle, sheep, pigs – Overt illness rare – Lesions suggestive of self-limited pulmonary infection seen at slaughter Center for Food Security and Public Health, Iowa State University, 2013
Disease in Other Species • Llamas – Particularly susceptible – Disseminated disease • Other species – Cattle, sheep, pigs – Overt illness rare – Lesions suggestive of self-limited pulmonary infection seen at slaughter Center for Food Security and Public Health, Iowa State University, 2013
 Morbidity and Mortality: Horses, Ruminants, Pigs • Horses – 4% healthy horses seropositive in endemic regions • Cattle – Lesions detected at slaughter • 5 -15% in Arizona, 2. 5% in Mexico – 14% seropositive in Mexico • Swine – 12% seropositive in Mexico Center for Food Security and Public Health, Iowa State University, 2013
Morbidity and Mortality: Horses, Ruminants, Pigs • Horses – 4% healthy horses seropositive in endemic regions • Cattle – Lesions detected at slaughter • 5 -15% in Arizona, 2. 5% in Mexico – 14% seropositive in Mexico • Swine – 12% seropositive in Mexico Center for Food Security and Public Health, Iowa State University, 2013
 Disease in Other Animals • Asymptomatic lesions occur in wide variety of species – Captive exotic animals • Canids • Felids • Bats • Wallabies • Kangaroos • Tapirs • Non-human primates Center for Food Security and Public Health, Iowa State University, 2013
Disease in Other Animals • Asymptomatic lesions occur in wide variety of species – Captive exotic animals • Canids • Felids • Bats • Wallabies • Kangaroos • Tapirs • Non-human primates Center for Food Security and Public Health, Iowa State University, 2013
 Post Mortem Lesions • Lungs – Variable foci of inflammation • Discrete nodules • Firm, grayish cut surface • Mineralized foci • Effusions – Slightly cloudy, tinged red • Lymph nodes – Firm, swollen Center for Food Security and Public Health, Iowa State University, 2013
Post Mortem Lesions • Lungs – Variable foci of inflammation • Discrete nodules • Firm, grayish cut surface • Mineralized foci • Effusions – Slightly cloudy, tinged red • Lymph nodes – Firm, swollen Center for Food Security and Public Health, Iowa State University, 2013
 Diagnosis in Animals • Multiple tests may be required – Cytology – Histopathology – Culture – Serology – Radiographs – Other advanced imaging • Trial with antifungal drugs Center for Food Security and Public Health, Iowa State University, 2013
Diagnosis in Animals • Multiple tests may be required – Cytology – Histopathology – Culture – Serology – Radiographs – Other advanced imaging • Trial with antifungal drugs Center for Food Security and Public Health, Iowa State University, 2013
 Diagnosis in Animals: Direct Observation • Visualization of parasite – Tissues, exudates, transtracheal or bronchoalveolar lavage fluids, lymph nodes, pleural fluids • Spherules – Double-walled – Most 20 -80 μm – Contain endospores • Multiple stains effective Center for Food Security and Public Health, Iowa State University, 2013
Diagnosis in Animals: Direct Observation • Visualization of parasite – Tissues, exudates, transtracheal or bronchoalveolar lavage fluids, lymph nodes, pleural fluids • Spherules – Double-walled – Most 20 -80 μm – Contain endospores • Multiple stains effective Center for Food Security and Public Health, Iowa State University, 2013
 Diagnosis in Animals: Culture • Body fluids, exudates, tissues • In-house culture not advised • Selective and non-selective media • Colony morphology – Older colonies • Floccose, white or buff, variable texture • Arthroconidia – Barrel-shaped, 2 -4 μm wide, multinucleated Center for Food Security and Public Health, Iowa State University, 2013
Diagnosis in Animals: Culture • Body fluids, exudates, tissues • In-house culture not advised • Selective and non-selective media • Colony morphology – Older colonies • Floccose, white or buff, variable texture • Arthroconidia – Barrel-shaped, 2 -4 μm wide, multinucleated Center for Food Security and Public Health, Iowa State University, 2013
 Diagnosis in Animals: Serology • Techniques and interpretation not well established in animals • Assays – AGID (most used) – ELISA – Latex particle agglutination • Ig. M: 2 -5 weeks; Ig. G: 8 -12 weeks • Ig. G titer not linked to severity Center for Food Security and Public Health, Iowa State University, 2013
Diagnosis in Animals: Serology • Techniques and interpretation not well established in animals • Assays – AGID (most used) – ELISA – Latex particle agglutination • Ig. M: 2 -5 weeks; Ig. G: 8 -12 weeks • Ig. G titer not linked to severity Center for Food Security and Public Health, Iowa State University, 2013
 Treatment in Animals • Antifungal drugs – Common practice – Regimen can be problematic • Adverse effects • Long term treatment required – Useful drugs • Amphotericin B, Ketoconazole, Itraconazole, Fluconazole Center for Food Security and Public Health, Iowa State University, 2013
Treatment in Animals • Antifungal drugs – Common practice – Regimen can be problematic • Adverse effects • Long term treatment required – Useful drugs • Amphotericin B, Ketoconazole, Itraconazole, Fluconazole Center for Food Security and Public Health, Iowa State University, 2013
 PREVENTION AND CONTROL
PREVENTION AND CONTROL
 Prevention in Humans • Difficult to prevent in endemic areas • Dust control – Pave dirt roads – Seed lawns – Dampen dust with oil • Prophylactic drug treatment • Screen transplant patients • No vaccine available Center for Food Security and Public Health, Iowa State University, 2013
Prevention in Humans • Difficult to prevent in endemic areas • Dust control – Pave dirt roads – Seed lawns – Dampen dust with oil • Prophylactic drug treatment • Screen transplant patients • No vaccine available Center for Food Security and Public Health, Iowa State University, 2013
 Prevention in Humans • Transmission via animal and humans very rare – Still, follow ordinary safety precautions • Fomites – Clean and disinfect – Destroy if cannot be decontaminated • Laboratory – Do not culture in-house – BSL 2 or 3 required Center for Food Security and Public Health, Iowa State University, 2013
Prevention in Humans • Transmission via animal and humans very rare – Still, follow ordinary safety precautions • Fomites – Clean and disinfect – Destroy if cannot be decontaminated • Laboratory – Do not culture in-house – BSL 2 or 3 required Center for Food Security and Public Health, Iowa State University, 2013
 Prevention in Animals • Limit animal’s exposure to large concentrations of arthroconidia – Desert soils – Areas of soil disturbance – Dust storms following rain – Other dusty conditions • No vaccine available Center for Food Security and Public Health, Iowa State University, 2013
Prevention in Animals • Limit animal’s exposure to large concentrations of arthroconidia – Desert soils – Areas of soil disturbance – Dust storms following rain – Other dusty conditions • No vaccine available Center for Food Security and Public Health, Iowa State University, 2013
 Disinfection • Halogens – Iodine – Chlorine • Hypochlorite/bleach • Phenolics • Quaternary ammonium compounds • Moist heat – 121°C for a minimum of 15 minutes Center for Food Security and Public Health, Iowa State University, 2013
Disinfection • Halogens – Iodine – Chlorine • Hypochlorite/bleach • Phenolics • Quaternary ammonium compounds • Moist heat – 121°C for a minimum of 15 minutes Center for Food Security and Public Health, Iowa State University, 2013
 Additional Resources • Center for Food Security and Public Health – www. cfsph. iastate. edu • Centers for Disease Control and Prevention – http: //www. cdc. gov/fungal/coccidioidomycosis/ • Valley Fever Center for Excellence, University of Arizona – https: //www. vfce. arizona. edu/Default. aspx Center for Food Security and Public Health, Iowa State University, 2013
Additional Resources • Center for Food Security and Public Health – www. cfsph. iastate. edu • Centers for Disease Control and Prevention – http: //www. cdc. gov/fungal/coccidioidomycosis/ • Valley Fever Center for Excellence, University of Arizona – https: //www. vfce. arizona. edu/Default. aspx Center for Food Security and Public Health, Iowa State University, 2013
 Acknowledgments Development of this presentation was made possible through grants provided to the Center for Food Security and Public Health at Iowa State University, College of Veterinary Medicine from the Centers for Disease Control and Prevention, the U. S. Department of Agriculture, the Iowa Homeland Security and Emergency Management Division, and the Multi-State Partnership for Security in Agriculture. Authors: Kerry Leedom Larson, DVM, MPH, Ph. D, DACVPM; Anna Rovid Spickler, DVM, Ph. D Reviewer: Glenda Dvorak, DVM, MPH, DACVPM
Acknowledgments Development of this presentation was made possible through grants provided to the Center for Food Security and Public Health at Iowa State University, College of Veterinary Medicine from the Centers for Disease Control and Prevention, the U. S. Department of Agriculture, the Iowa Homeland Security and Emergency Management Division, and the Multi-State Partnership for Security in Agriculture. Authors: Kerry Leedom Larson, DVM, MPH, Ph. D, DACVPM; Anna Rovid Spickler, DVM, Ph. D Reviewer: Glenda Dvorak, DVM, MPH, DACVPM


